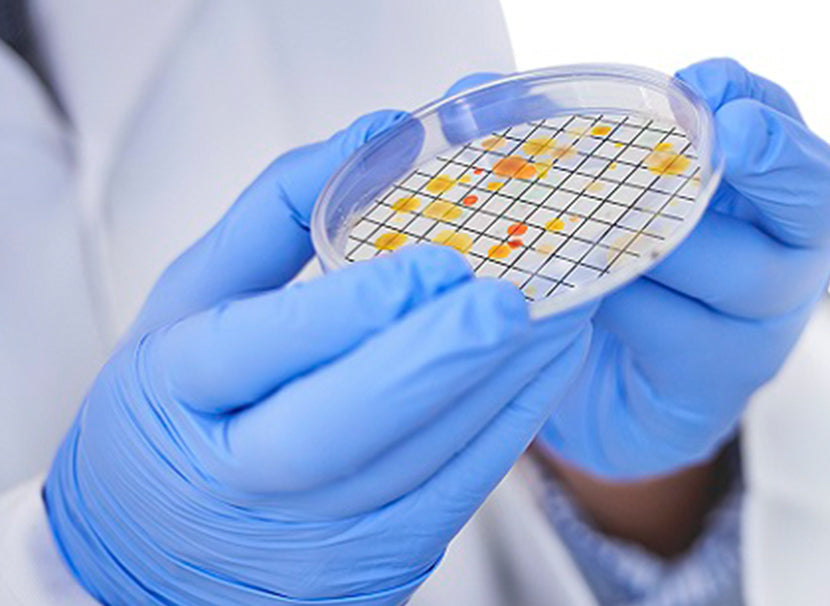
ライフサイエンス

GVSジャパン株式会社
GVSグループは、ヘルスケア、ライフサイエンス、自動車、家電製品、セーフティマスク、商業および産業用濾過材の各分野で使用されるフィルターとコンポーネントの世界的なリーディングカンパニーです。
GVSグループは、国際化という明確な戦略を通じ、イタリア、英国、ブラジル、米国、中国、ルーマニアで12の製造工場を設立し、またロシア、トルコ、アルゼンチン、日本、韓国に事業所を開設しています。
GVSは、現在世界全体で2,700人余りの従業員を擁しています。GVSは40年間、製品群と製造プロセスの革新に注力しており、顧客に最高のサービスとサポートをお届けできるよう、絶えず開発能力の向上に努めています。

注目商品

SEPARA® シリンジレスフィルターを使って、サンプル作製プロセスに必要な時間と経費を節約しましょう。
シングルステップのろ過プロセスは、高効率且つ取り扱いが簡単で、プレスしやすく、迅速に使用できます。
このデバイスは、メンブレンチャンバーを備えた内部バイアルと、ろ液を注入するための外部バイアルの2つの部分から構成されています。
サンプル液は外部バイアルに注入し、内部バイアルを押し込むことでろ過が完了し、オートサンプラーに掛ける準備が整います。
注目商品

貫通した孔が開いた絶対孔径を持ち、ろ過により捕捉された物質を光学あるいは電子顕微鏡で観察する事ができます。
膜素材はポリカーボネートとポリエステルの2種類があり、高純度が必要なろ過用途だけでなく、細胞ベースのろ過アッセイでの使用にも理想的です。
膜は、独自の製造プロセスの2段階で製造されます。薄い半透明な膜は、滑らかで平坦なガラスのような表面を持つため顕微鏡による観察性が高く、細孔サイズより大きい粒子が100%膜の表面に捕捉されます。
注目商品

GVSのCentrifugal Filterは10-100kDの分画分子量を持つ遠心式フィルターユニットです。
各種タンパク質などを含む溶液を分注し、遠心分離をかけることで容易に試料を濃縮・脱塩・バッファー交換できます。
幅広い化学的適合性:ヒートシールされたメンブレンにより、接着剤や溶出物が排除されます。
pH 1~9にて使用可能です。
低結合膜およびポリプロピレンハウジングにより90%を超えるサンプル回収が可能です。
アプリケーション
抗原、抗体、酵素などの試料の濃縮
精製後タンパク質溶液の脱塩・濃縮・バッファー交換
ニュース&トピック

2025.12.04 LIFE SCIENCES GVSライフサイエンス部門は、12月3日(水)~5日(金)3日間 パシフィコ横浜にて行われる第48回日本分子生物学会2025附設展示会に参加します。 フルオートクレーブ対応マイクロピペット FLAME PETTEを株式会社セツロテック様ブースにて展示いたします。 会場では実際にデモ機をご覧になって頂けるほか、株式会社セツロテック様からのおとく...
もっと見る

2025.09.03 LIFE SCIENCES 幕張メッセで開催中のJASIS2025、本日は17時までです。GVSブースではデモや無料サンプルの進呈を行なっております。是非お気軽にお立ち寄りください。 会場案内図(GVSブース):8B-304
もっと見る